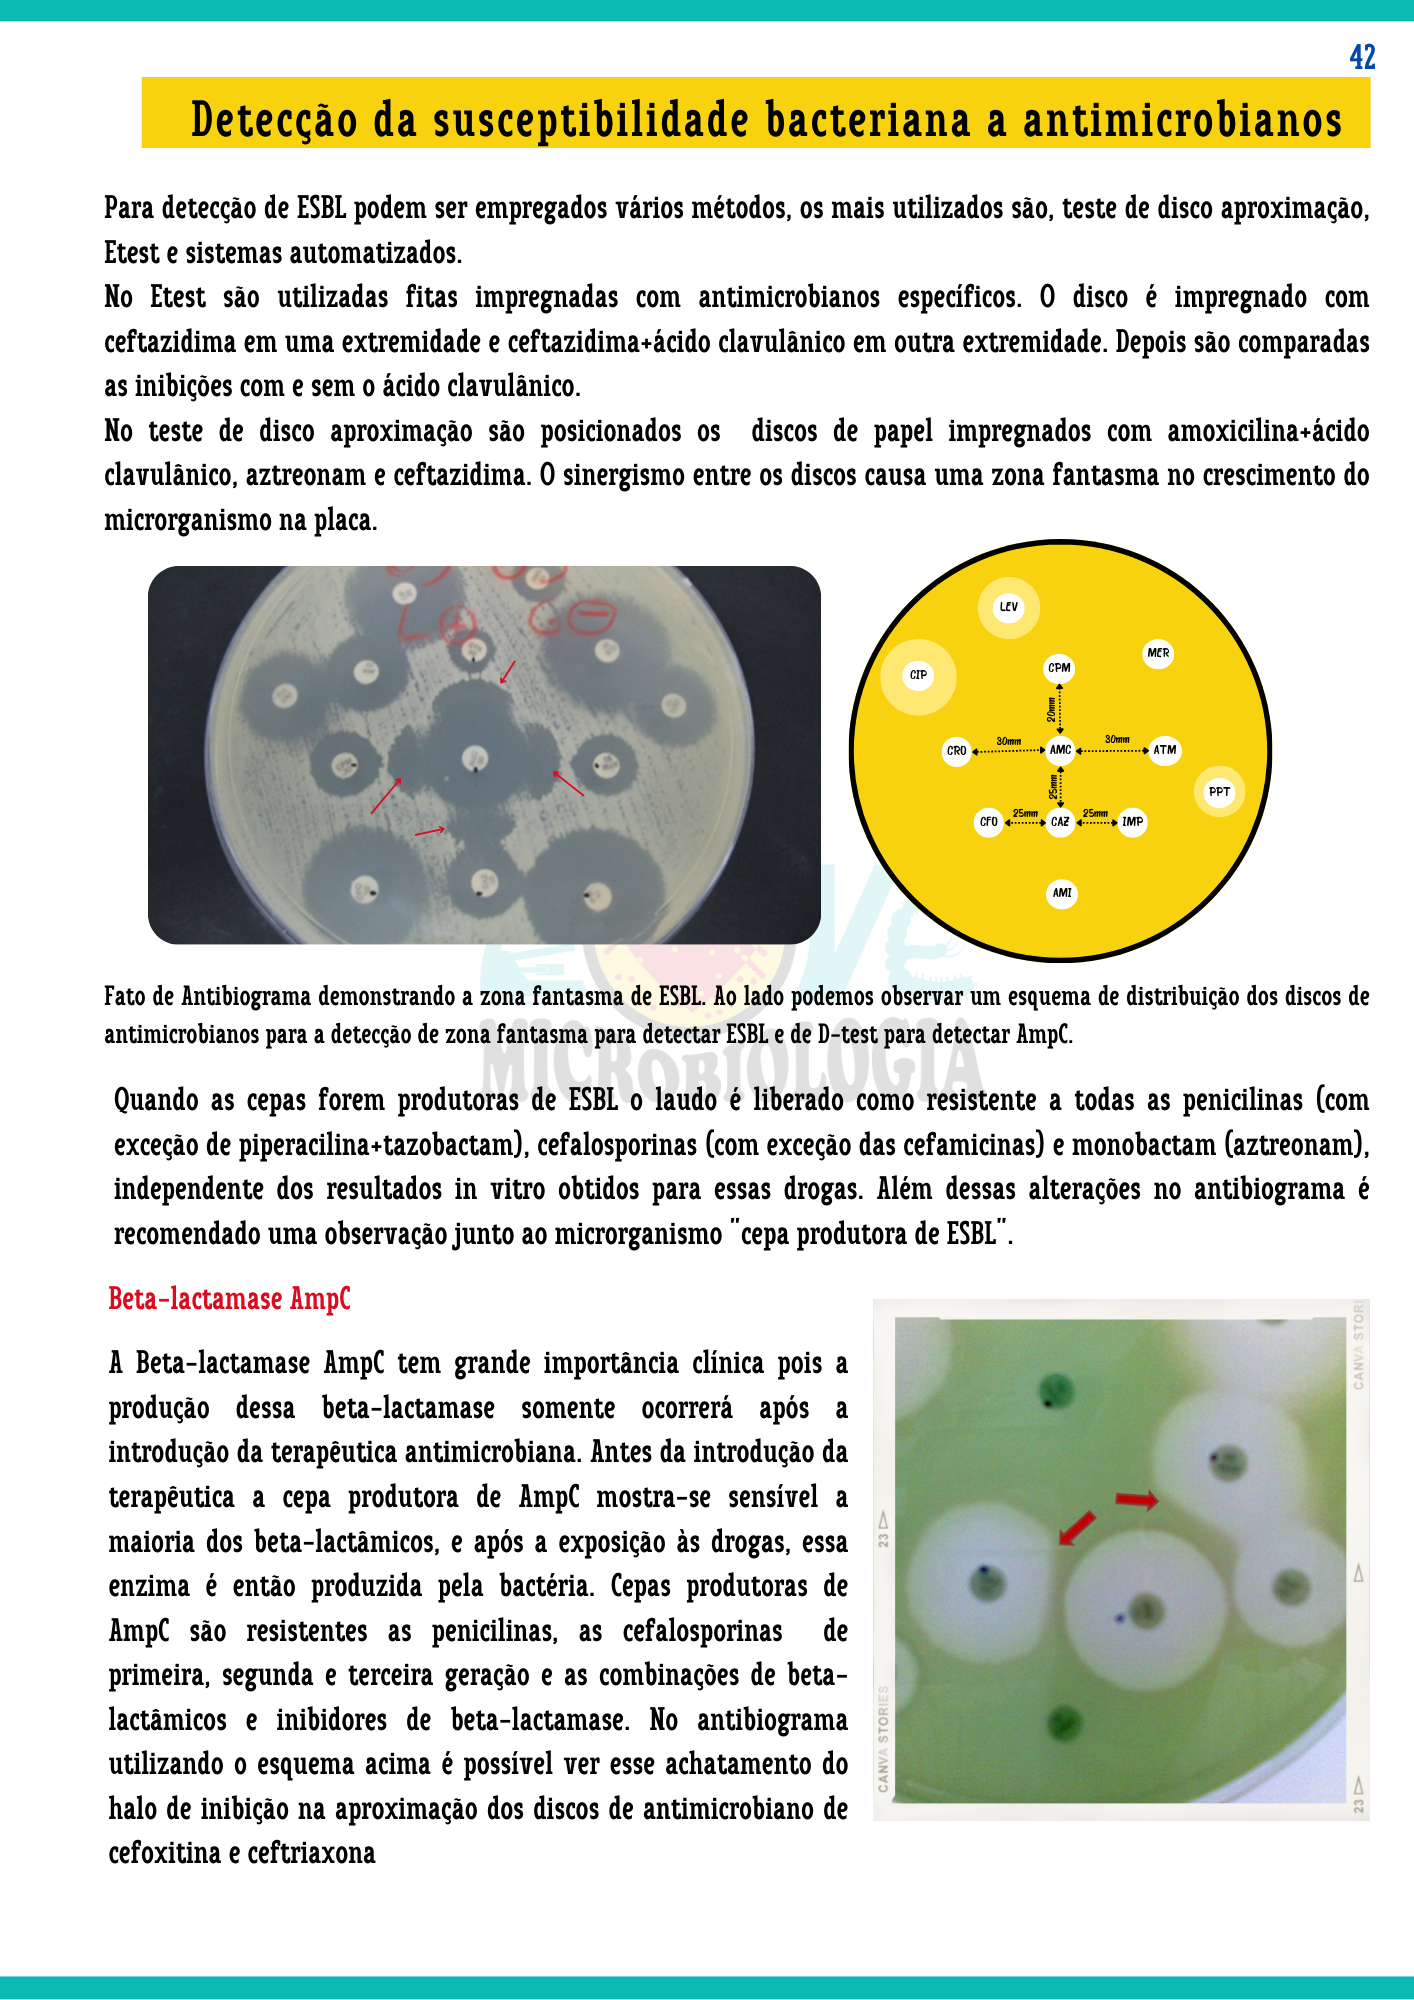
Resumos de Microbiologia Clínica (11)

ESTUDE MICROBIOLOGIA CLÍNICA DE FORMA FÁCIL E SEM ENROLAÇÃO
Aprenda MICROBIOLOGIA BÁSICA, CLÍNICA, e PRÁTICA EM LABORATÓRIO, com resumos ILUSTRADOS, DIDÁTICOS e ESQUEMATIZADOS, sem livros gigantes e cansativos.

Esse MATERIAL é para você que:
- Quer aprender Microbiologia de forma simples e em menos tempo;
- Esquece tudo que estudou:
- Quer economizar tempo de estudo para se dedicar a outras atividades
- Não consegue revisar suas próprias anotações;
Toque no botão abaixo para adquirir seus materiais AGORA!

PORQUE ESTUDAR POR RESUMOS É TÃO EFICIENTE?




POR DENTRO DOS PDFs!
Confira algumas amostras dos PDFs que você irá adquirir.

CONFIRA O CONTEÚDO!

RESUMOS DE MICROBIOLOGIA CLÍNICA
Material em PDF.
Receba imediatamente.
São 60 páginas que abordam:
Introdução à Microbiologia clínica;
Controle dos Microrganismos;
Coleta de material biológico;
Morfologia e fisiologia bacteriana;
Técnicas de Microscopia;
Meios de cultura;
Tipos de semeaduras;
Genética bacteriana;
Principais bactérias de interesse médico;
Identificação das principais bactérias de interesse médico;
Resistência bacteriana à antimicrobianos
Micologia;
Virologia
Adquirindo seus resumos hoje você ainda receberá..

BÔNUS 1 - Mapas Mentais de Doenças Infecciosas e Parasitárias
Aprenda tudo sobre as Doenças Infecciosas e Parasitárias com os mapas mentais que me fizeram ser aprovada na seleção de mestrado.
Material em PDF.
Material 100% atualizado!
Assuntos: Dengue, Diarreias infecciosas; Hepatites; Herpes; HIV/aids; Sarampo; Esquistossomose; Giardíase; Toxoplasmose; Tuberculose.
Esses mapas custariam: R$59,90. Mas você receberá gratuitamente ao adquirir os resumos.
*Os Mapas ficam disponíveis 7 dias após a confirmação do pagamento.

BÔNUS 2 - Questões de Microbiologia para concurso
Material em PDF.
15 questões
Toque no botão abaixo para adquirir seus materiais AGORA!
Junte-se a mais de 400 estudantes!
O QUE ESTÃO FALANDO SOBRE OS MATERIAIS




Tenha acesso agora mesmo a este material digital em PDF + 2 bônus exclusivo
De R$87,70 por apenas:
6X de
R$7,89
ou R$42,90 á vista

ESTUDE MICROBIOLOGIA CLÍNICA DE FORMA FÁCIL E SEM ENROLAÇÃO
Aprenda MICROBIOLOGIA BÁSICA, CLÍNICA e PRÁTICA EM LABORATÓRIO, com resumos ILUSTRADOS, DIDÁTICOS e ESQUEMATIZADOS, sem livros gigantes e cansativos.

Esse MATERIAL é para você que:
- É estudante de cursos da área da saúde, como Medicina, Biomedicina, Farmácia e Enfermagem;
- Quer aprender Microbiologia de forma simples e em menos tempo;
- Esquece tudo que estudou:
- Quer economizar tempo de estudo para se dedicar a outras atividades
- Não consegue revisar suas próprias anotações;

POR QUE ESTUDAR PELOS RESUMOS DE MICROBIOLOGIA CLÍNICA?




CONHEÇA O MATERIAL POR DENTRO!






O QUE VOCÊ RECEBERÁ

Resumos de Microbiologia clínica
Material em PDF
Receba imediatamente*
São 60 páginas que abordam:
Introdução à Microbiologia clínica;
Controle dos microrganismos;
Coleta de material biológico;
Morfologia e fisiologia bacteriana;
Técnicas de microscopia;
Meios de cultura;
Tipos de semeaduras;
Genética bacteriana;
Principais bactérias de interesse médico;
Identificação das principais bactérias de interesse médico;
Resistência bacteriana à antimicrobianos;
Micologia;
Virologia
Adquirindo hoje você ainda receberá..

Bônus 1 - Mapas Mentais de Doenças infecciosas e Parasitárias
Aprenda tudo sobre as Doenças Infecciosas e Parasitárias com os mapas mentais que me fizeram ser aprovada na seleção de mestrado.
Material em PDF
Material 100% atualizado!
Conteúdo: Dengue; Diarreias infecciosas; Hepatites; Herpes; HIV/aids; Sarampo; Esquistossomose; Giardíase; Toxoplasmose; Tuberculose.
Esses mapas custariam: R$ 59,90. Mas
você irá receber gratuitamente ao adquirir os Resumos.
.

Bônus 2 - Questões de Microbiologia para Concursos
15 questões
Material em PDF
VEJA O QUE VOCÊ RECEBERÁ NESSE MATERIAL:
São 60 páginas de conteúdo;
- Introdução à Microbiologia clínica;
- Controle dos microrganismos;
- Coleta de material biológico;
- Morfologia e fisiologia bacteriana;
- Técnicas de microscopia;
- Meios de cultura;
- Tipos de semeaduras;
- Genética bacteriana;
- Principais bactérias de interesse médico;
- Identificação das principais bactérias de interesse médico;
- Resistência bacteriana à antimicrobianos;
- Micologia;
- Virologia.
+ Bônus
Mapas mentais de Doenças infecciosas e parasitárias
QUEM COMPROU APROVOU!





Tenha acesso agora mesmo a este material + bônus exclusivos
De R$87,70 por apenas
6X de
R$7,89
ou R$ 42,90 à vista

ELIZABETH BELTRÃO
Bióloga, professora, mestra e doutora em Medicina tropical pela Universidade Federal de Pernambuco-UFPE. Investigadora científica por vocação. Apaixonada por Microbiologia e Biologia molecular. Acredito que o conhecimento científico deve ser divulgado com linguagem mais simples e prática. Com 12 anos de experiência na vida acadêmica. Idealizadora do perfil Lovemicrobiologia no instagram, criado a 6 anos e conta com mais de 14 mil seguidores.

ELIZABETH BELTRÃO
Bióloga, professora, mestra e doutora em Medicina tropical pela Universidade Federal de Pernambuco-UFPE. Investigadora científica por vocação. Apaixonada por Microbiologia e Biologia molecular. Acredito que o conhecimento científico deve ser divulgado com linguagem mais simples e prática. Com 12 anos de experiência na vida acadêmica. Idealizadora do perfil Lovemicrobiologia no instagram, criado a 6 anos e conta com mais de 14 mil seguidores.

Perguntas frequentes:
Você receberá o acesso do seu material por e-mail, após a confirmação do pagamento.
O material é digitalizado em formato pdf e tamanho A4. A impressão é opcional do cliente.
É perfeito para quem ainda está na faculdade. O material foi elaborado com a finalidade de facilitar os estudos dos universitários da área de saúde (como, biomedicina, medicina, enfermagem, nutrição, farmácia, ciências biológicas e cursos para técnico de laboratório também), mas também pode ser utilizado por estudantes de outros cursos.
Sim. Os resumos são completos e servem tanto para universitários como para estudantes de curso técnico em laboratório.
Pix, cartão de crédito e boleto.
*A opção de parcelamento está disponível apenas por cartão de crédito e com acréscimo de juros.
Sim. O material foi elaborado a partir de versões mais atuais de livros, artigos, notas técnicas da ANVISA e BrCast.
Não. O material é de uso exclusivo da pessoa que o adquiriu. ortanto, é proibido o compartilhamento e/ou comercializar este material. O compartilhamento e/ou comercialização deste material é previste em lei como crime de direitos autorais, art. 184 do código penal brasileiro, com pena de 3 meses a 4 anos de reclusão ou multa.
Sim. Damos garantia de reembolso de 7 dias a partir da confirmação do pagamento. Dentro dos 7 dias o seu pedido de reembolso é autorizado automaticamente pelo sistema e sem burocracia.
Neste caso, você pode entrar em contato conosco pelo e-mail: lovemicrobiologiainst@gmail.com ou pelo whatsapp: (082) 9 9917-3718.
lovemicrobiologiainst@gmail.com
©Copyright 2022 LoveMicrobiologia, Todos os direitos reservados